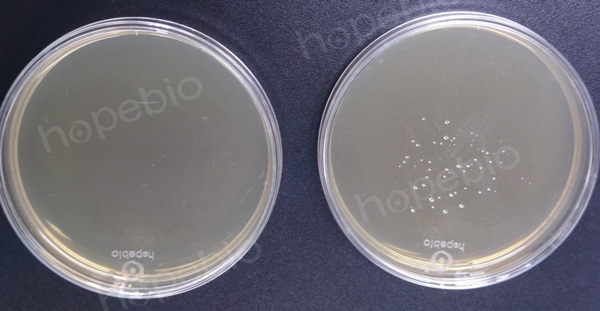

海博微信公众号
海博微信公众号
 海博天猫旗舰店
海博天猫旗舰店


 海博微信公众号
海博微信公众号
 海博天猫旗舰店
海博天猫旗舰店




在微生物实验中,培养基平皿放置后出现冷凝水是常见现象,但其可能影响菌落分离效果或导致污染。以下是冷凝水形成的原因及改进措施:
一、培养基平皿冷凝水形成的原因
1. 温度骤降
当熔化的高温培养基(约50℃~60℃)倒入室温或低温的平皿时,培养基表面热量快速散失,导致水蒸气在皿盖内壁冷凝。若实验室湿度较大,水蒸气更易在皿盖凝结。
2. 培养基成分与制备问题
培养基中琼脂浓度过低(如<1.5%)会导致凝固不充分,游离水分增多。当培养基未充分溶解或混匀时,未完全熔化的琼脂颗粒或未混匀的培养基可能局部聚集水分。
3. 储存条件不当
平皿叠放或密封保存时,叠放时底部平皿受压,或密封包装阻碍水分蒸发,均可能会导致冷凝水积聚。其次冷藏保存的平皿取出后,若未回温直接使用,产生的温差也可能会导致冷凝水生成。
二、培养基减少冷凝水的方法
1. 控制培养基温度与倒皿操作
降温至适宜温度:熔化后的培养基冷却至46℃~50℃(手触瓶壁微烫但不烫手时)再倒入平皿。
预热平皿:倒皿前将无菌平皿置于37℃培养箱或超净台内预热10~15分钟,减少温差。
缓慢倒皿:沿平皿边缘缓慢倒入培养基,避免剧烈晃动产生气泡。
2. 优化培养基制备
调整琼脂浓度:常规培养基琼脂含量建议为1.5%~2.0%(如营养琼脂),高湿度环境可适当提高至2.2%。
充分溶解与混匀:加热时搅拌至琼脂完全熔化,避免局部结块;倒平皿前轻摇混匀培养基。
3. 改进平皿干燥与储存方式
倒置凝固与干燥:培养基凝固后,将平皿放置于超净台中,打开皿盖,使用风机大风吹去水汽(需要打开紫外灯),一般当天使用的培养基可吹风20分钟左右,次日使用的平皿可吹风10分钟左右,吹风时间因培养基种类和用法不一而有不同,可通过预实验探究最佳吹风时间,防止培养基过于干燥。若无超净台,可将平皿倒置(皿盖在下),使冷凝水自然流至皿盖,并由边缘流出,避免其接触培养基表面。
图1 吹风前含有水汽的平皿和吹风后无水汽的平皿
储存条件优化:平皿单独平放或少量叠放(不超过5个),避免挤压导致水分渗出。若需冷藏保存,使用前提前取出,室温平衡30分钟后再使用。
4. 环境湿度控制
实验室湿度控制在40%~60%,使用除湿机或空调调节。尽量避免在雨天或高湿度环境下倾倒培养基。
5. 特殊处理(必要时)
二次干燥:将凝固后的平皿放入37℃培养箱(倒置)干燥1~2小时,彻底去除冷凝水。
使用吸水纸:在皿盖内壁贴无菌滤纸片(需验证无菌性),吸收冷凝水。
三、总结
通过控制培养基温度、优化储存条件、调整琼脂浓度及环境湿度,可有效减少或消除平皿冷凝水。实际操作中需结合实验室条件灵活选择方法,确保培养基质量与实验结果的可靠性。
四、注意事项
避免过度干燥:过度干燥可能导致培养基开裂或营养成分损失,干燥时间需根据培养基类型调整。
无菌操作:干燥或储存过程中需保持平皿密封,防止污染。
验证效果:改进后需通过空白培养试验验证冷凝水是否影响实验结果。
注:本文属海博生物原创,未经允许不得转载。
| 相关文章: | ||



